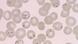
Blood smear with malaria parasites under the microscope Photo: Bernhard-Nocht-institute Blood smear with malaria parasites under the microscope Photo: Bernhard-Nocht-institute

Rapid diagnosis
March 11, 2014
The Fraunhofer Institute for Integrated Circuits has been developing a prototype of an automated microscopy system to diagnose malaria. A white box containing a microscope is linked to a computer, and all a medical assistant has to do is introduce a cartridge with ten slides.
The system scans the slides, one at a time, Andreas Reimann, head of the Fraunhofer Future Foundation Malaria Project, tells DW.
Hard to diagnose malaria with microscopes
To find out whether a patient is suffering from malaria, doctors apply a drop of his blood onto a microscope slide, color it with chemicals and then take a close look at it through a microscope.
Malaria parasites appear as dark-purple spots. But they can be hard to find, according to Sabine Nachtsheim, a medical technical assistant at University Hospital Bonn.
"Sometimes they are few and far between and it takes me a while to find them," she says.
And not everybody can do it.
"If you want to be sure whether it is a malaria parasite or not, you need to have practice," says Ernst Molitor, senior physician at the Institute of Medical Microbiology at University Hospital Bonn.
Replace experts with tech?
"There is high demand for automated help with malaria microscopy," says Andreas Reimann.
Relatively few people know how to do it properly, "so that even well-respected institutes like Oxford have to fly in experts from Africa to make these examinations," he adds.
So a machine could help fill the gap.
To examine the blood sample thoroughly, the board on which the microscope slides are attached move sideways, and up and down. The microscope will automatically focus on the target areas. A camera takes pictures of what can be seen through the microscope and stores them on a computer. Using algorithms, software will search the pictures for features typical for malaria parasites.
"In the end, the system will say, yes, there are parasites in the blood and how many. A doctor just has to control and confirm that - and the diagnosis is made," says Reimann.
This diagnosis based on digital pictures can even be done by an expert in another country.
Conveyor-belt microscopy
Analyzing one slide will take about ten minutes. So the system could save hospital personnel a lot of time, Reimann says.
It would especially help with clinical trials at large African centers testing a new malaria vaccine for example, he adds.
There aren't enough malaria experts for diagnosing malaria, especially in Europe and the US, according to Andrea Bosman, a coordinator at the World Health Organization's Global Malaria Programme.
Some companies are developing similar systems like the one Reimann and his team are working on, he says, while noting that the use of such systems is unlikely to become widespread.
According to Bosman, microscopy has got some limitations when it comes to diagnosing malaria. There has to be a sufficient number of parasites in one milliliter blood to be seen under a microscope. A machine that would simply read blood samples slides automatically will not improve the method itself.
But Reimann says that his system gives medical personnel the opportunity to scan the blood sample thoroughly. And even when there are just very few parasites in it, the system would not miss them, like a human being could, he adds.
Other malaria experts acknowledge that such a system would indeed be a good idea for use in clinical trials because the system would treat all blood samples in the same way. The results would not depend on the person working on that day.
Cheap and easy-to-use alternatives
It is unlikely that an automated microscopy system will take on in Africa because there are alternatives, according to the WHO's Bosman.
Small plastic stripes, point-of-care tests, can also be used to diagnose malaria. They are similar to a home pregnancy test. With a drop of blood, the test can reveal whether the patient is suffering from malaria within a few minutes. The test detects a substance that malaria parasites produce.
Disposable point-of-care tests are quite cheap. They only cost about 30 to 40 cents, according to Bosman. And they are very easy to use.
Doctors Without Borders almost completely relies on point-of-care testing for malaria. It hardly ever uses microscopy. But physician Ernst Molitor warns against relying on the disposable tests.
"The sensitivity of these tests is somewhat lower than a microscope. You can get a negative result when the malaria is still in its beginning and the concentration of parasites in the blood is not very high. Out of 100 patients who suffer from malaria, an average of five will get a negative test result," he says
"No one wants to be any of the five," the physician adds.